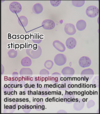

Chapter 14: Anemias Flashcards
(117 cards)
In general, what are macrocytic vs. microcytic anemias each caused by?
- Macrocytic = abnormalities that impair maturation of erythroid precursors in the bone marrow
- Microcytic = disorders of hemoglobin synthesis (most often iron deficiency)
Which mean cell volume (fL) is indicative of micro- vs. macrocytic anemia?
- MCV <80 = microcytic
- MCV >100 = macrocytic
What does an elevated Red Cell Distribution Width (RDW) tell us?
- That marrow is pumping out reticulocytes (larger cells)
- Elevated RDW is a reactive phenomenon observed in states of anemia with a functioning marrow
Which changes are seen in red cells, white cells, and platelets with acute blood loss?
- Leukocytosis
- Reticulocytosis
- Thrombocytosis
A male or post-menopausal female presenting with iron-deficiency anemia is indicative of what until proven otherwise?
GI tract lesion
Hemolytic anemias share what 3 features?
- A shortened red cell life span below typical 120 days
- ↑ EPO levels and compensatory ↑ in erythropoiesis
- Accumulation of hemoglobin degradation products as part of red cell hemolysis
What ar the 3 principal clinical features of extravascular hemolysis?
- Anemia
- Splenomegaly
- Jaundice

Patients with extravascular hemolysis often benefit from what?
Splenectomy due to much of the pathologic destruction of RBC’s occurring in the spleen
What are the 5 main manifestations of intravascular hemolysis?
- Anemia
- Hemoglobin-emia
- Hemoglobin-uria
- Hemosiderin-uria
- Jaundice

In all types of uncomplicated hemolytic anemias, the excess serum bilirubin is of what type?
Unconjugated

What happens to the levels of serum haptoglobin with extra- and intravascular hemolysis?
- Extravascular = variably decreased as some Hgb escapes phagocytes
- Intravascular = becomes markedly reduced–> freeHgboxidizes tomethemoglobin
Regardless of the cause of type of hemolytic anemia what morphological changes are seen in the peripheral blood and BM?
- ↑ numbers of erythroid precursors (normoblasts) in the marrow
- Prominent reticulocytosis in the peripheral blood
With chronic hemolysis, elevated biliary excretion of bilirubin promotes what?
Formation of pigment gallstones (cholelithiasis)
Hereditary spherocytosis is an inherited disorder caused by intrinsic defects in what?
Red cell membrane skeleton –> cells are spheroid, less deformable, and vulnerable to splenic sequestration

What is the inheritance pattern of hereditary spherocytosis; prevalence is highest where?
Autosomal Dominant (75% of cases); highest in Northern Europe
What is the characteristic morphology of the red cells seen on smears in pt with hereditary spherocytosis?
Small, dark-staining (hyperchromic) red cell lacking central zone of pallor

Characteristc morphology of the spleen in hereditary spherocytosis?
Moderate splenomegaly (500-1000 gm)
Red cells of hereditary spherocytosis are abnormally sensitive to what; what is the MCHC finding?
- Osmotic lysis when incubated w/ hypotonic salt solution
- HS red cells also have ↑ MCHC, due to dehydration caused by loss of K+ and H2O
Characteristic clinical findings of hereditary spherocytosis are what; some may be asymptomatic but most will have what type of anemia?
- Splenomegaly + jaundice + anemia +/- gallstones
- CHRONIC hemolytic anemia of mild to moderate severity

Aplastic crises occurring in the setting of hereditary spherocytosis is often triggered by what?
Parvovirus B19 infection (ssDNA virus)
How is the anemia and its complications in hereditary spherocytosis treated?
Splenectomy
What are the most common triggers responsible for the episodic hemolysis seen with G6PD deficiency?
- Infections: viral hepatitis, pneumonia, and typhoid fever
- Drugs: ASA, diphenhydramine, antimalarials, sulfonamides, and nitrofurantoins
- Foods: including simple CHO’s, tonic water, sulfites (wine and dried fruit), and fava beans** (endemic in Mediterranean, ME, and Africa)

The acute intravascular hemolysis is greater in pt’s with which variant of G6PD deficiency?
Mediterranean variant

What is seen 2-3 days following exposure of G6PD-deficienct pt’s to oxidants?
Acute intravascular hemolysis marked by anemia, hemoglobinemia, andhemoglobinuria